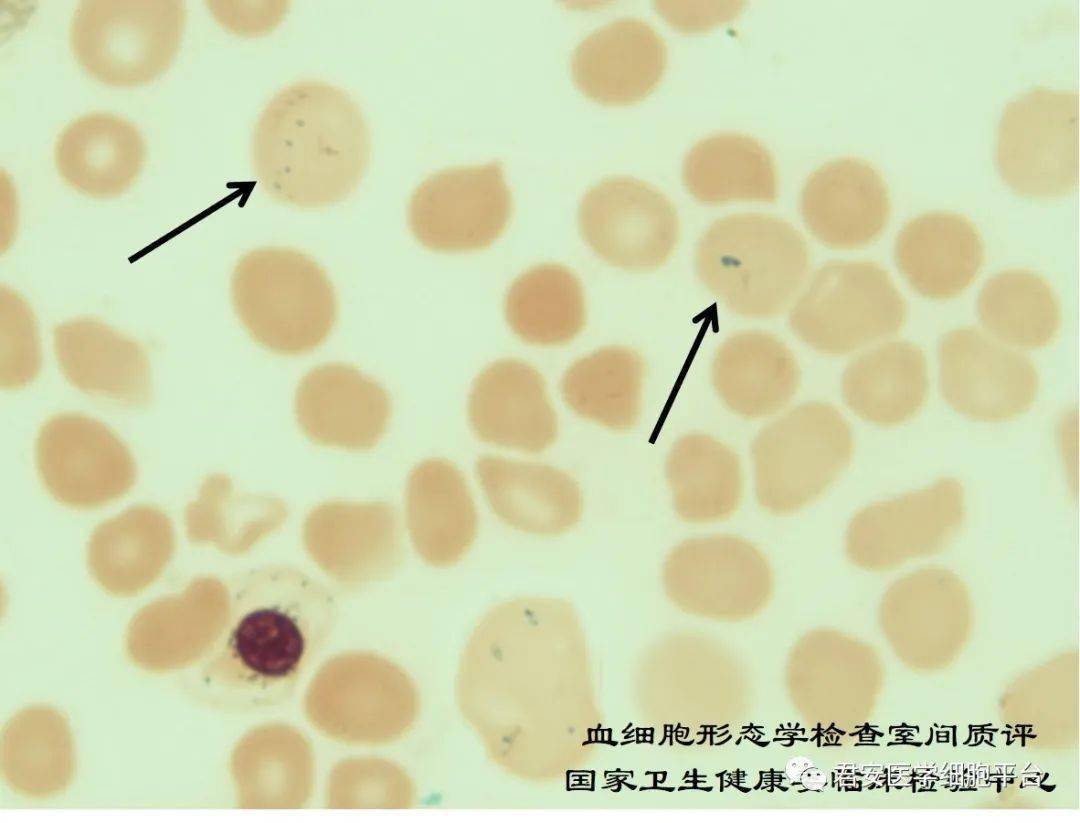
2021年第2次血细胞形态学检查室间质量评价_检验

皱缩红细胞

这应该是皱缩红细胞吧 - 标签数据维护版块 -丁香园论坛
图片尺寸432x576
急求正常红细胞显微镜下的照片和一张皱缩的照片,要真实的谢谢,论文用
图片尺寸800x600
如何区分棘形红细胞和皱缩红细胞?
图片尺寸1080x716
丁香园论坛
图片尺寸678x422
血液检测 - 美篇
图片尺寸1664x1040
【有奖读图】#显微镜下的美丽#和王霄霞老师一起学习细胞形态学(第九
图片尺寸736x566
历年尿液有形成分室间质评合辑(原卫生部临检中心)_网易订阅
图片尺寸650x488
红细胞检查_互动百科
图片尺寸140x108
【临床基本功】红细胞异常知多少4_中华医学网
图片尺寸504x335
血液学检验典型细胞图谱ppt_word文档在线阅读与下载_无忧文档
图片尺寸1080x810
《物质跨膜运输的实例》课件1(新人教版必修1)ppt_word文档在线阅读与
图片尺寸1080x810
猜图答案 - 美篇
图片尺寸1600x1200
2018细胞形态学培训考试答案版 - 美篇
图片尺寸2560x1765
一文读懂"尿液红细胞形态分析"_腾讯新闻
图片尺寸799x1000
红细胞是红色的吗? - 〓分子细胞〓 - 四哥生物论坛 - powered by dis
图片尺寸536x217
生物:4.1《物质跨膜运输的实例》课件(新人教版必修1)ppt_word文档在
图片尺寸1080x675
2021年第2次血细胞形态学检查室间质量评价_检验
图片尺寸1080x823
细胞形态图谱ppt_word文档在线阅读与下载_无忧文档
图片尺寸1080x810
《科学》子刊:红细胞还管免疫!科学家发现红细胞能识别炎症相关dna,诱
图片尺寸640x423
正常红细胞
图片尺寸1200x919